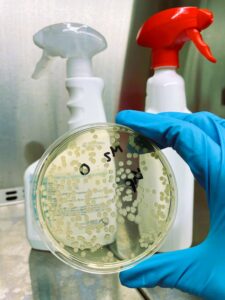

El laboratorio de Microbiología del área de Servicios Tecnológicos Avanzados (STA) de Leitat ha obtenido un nuevo expediente de acreditación de la Entidad Nacional de Acreditación (ENAC) dentro del sector sanitario, conforme a la norma ISO/IEC 17025.
Esta acreditación incluye los métodos EN 1276, EN 1650, EN 13697 y EN 13704 para la realización de ensayos de eficacia de desinfectantes, permitiendo evaluar la actividad bactericida, fungicida y esporicida en distintos tipos de productos.
Con esta ampliación, Leitat se convierte en el único centro tecnológico de Cataluña acreditado para realizar ensayos según estas normas. Asimismo, en el caso de la norma EN 13704, es el segundo laboratorio acreditado en España y el único ubicado en Cataluña.
Este avance refuerza la capacidad del centro para ofrecer servicios de evaluación microbiológica con garantías de calidad y fiabilidad, consolidando su compromiso con la industria en ámbitos clave como la seguridad y la eficacia de los productos desinfectantes.
El logro ha sido posible gracias al trabajo del equipo de microbiología, cuya dedicación y experiencia han sido clave para la consecución de esta nueva acreditación.






